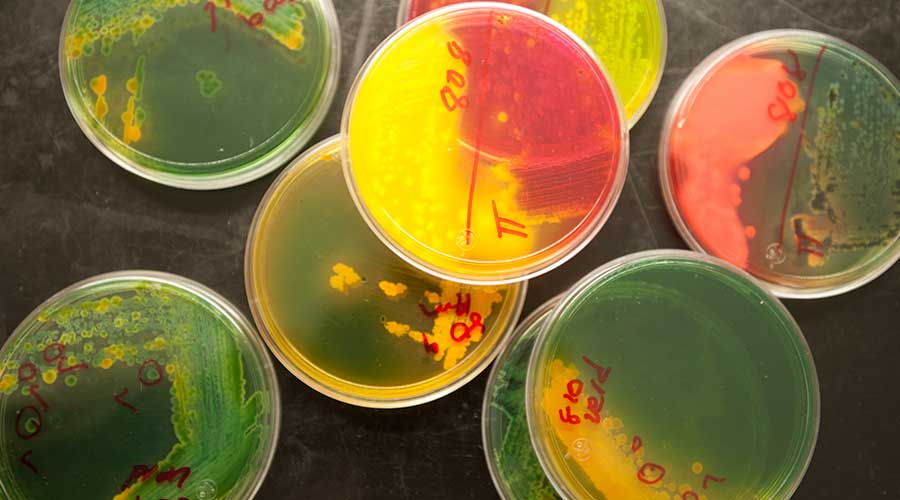
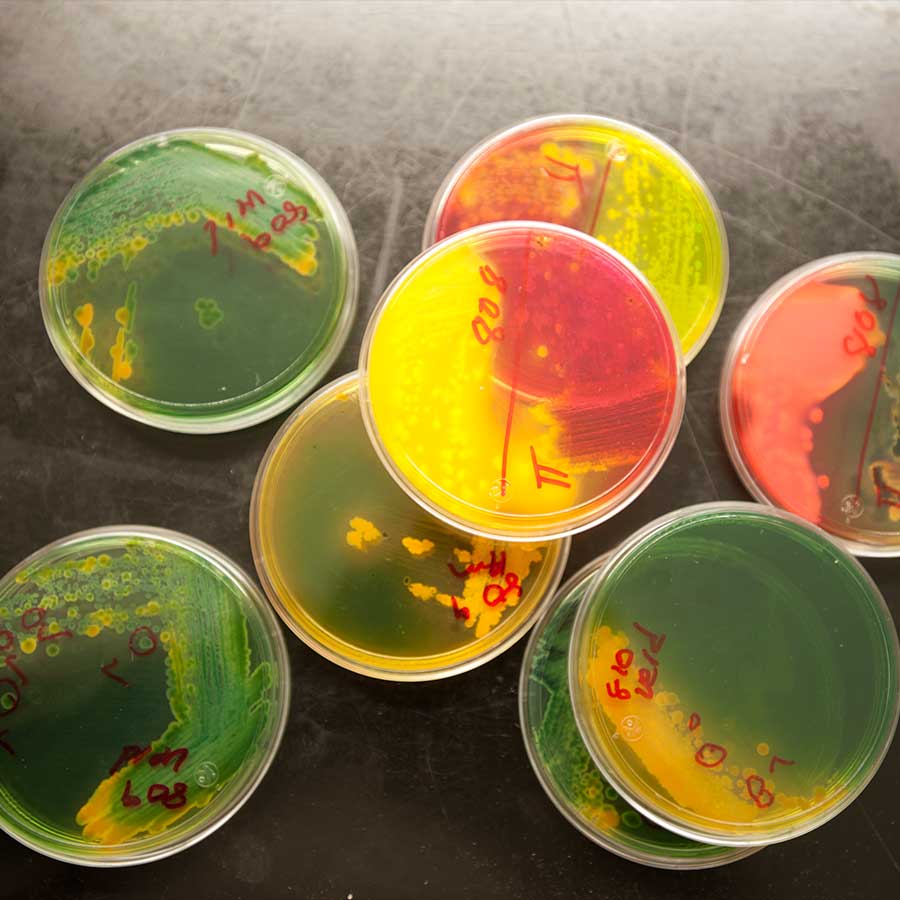

Tecnología de Productos Hortofrutícolas y Lácteos
Nuestro trabajo está íntimamente ligado con el sector agropecuario y agroindustrial a través del diseño de proyectos en colaboración con productores de frijol, cebolla, chile y leche, que son algunos de los principales productos de la región